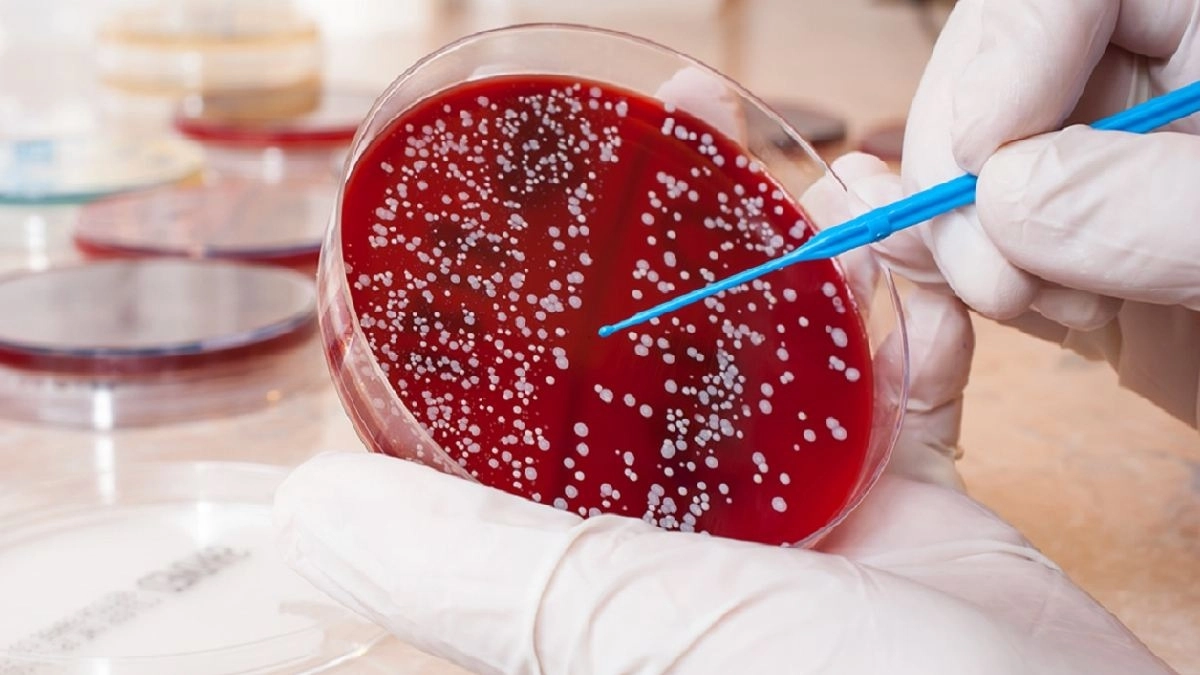

বৃহস্পতিবার ১৬ অক্টোবর ২০২৫
সম্পূর্ণ খবর
রিয়া পাত্র | ১৬ অক্টোবর ২০২৫ ১৬ : ৫২Riya Patra
আজকাল ওয়েবডেস্ক: গুজরাট। বিজেপি শাসিত রাজ্য। মোদির রাজ্য। সেই রাজ্যের মুখ্যমন্ত্রী ভূপেন্দ্র প্যাটেল ছাড়া বাকি সব মন্ত্রী পদত্যাগ করেছেন। মুখ্যমন্ত্রীর কাছে তাঁদের পদত্যাগপত্র জমা দিয়েছেন। মুখ্যমন্ত্রী সেই পদত্যাগপত্রগুলি গ্রহণ করেছেন। সর্বভারতীয় সংবাদ মাধ্যম সূত্রের খবর তেমনটাই।
স্বাভাবিকভাবেই এই ঘটনায় তীব্র চাঞ্চল্য দেশের রাজনীতিতে। কারণ কী? আলোচনায় নানা মত। গোষ্ঠী দ্বন্দ্ব? নেপালের মতোই কি তাহলে শীর্ষ পদাধিকারীর উপর থেকে আস্থা হারিয়েছেন ক্যাবিনেটের বাকি সদস্যরা? যদিও উত্তর মিলেছে ইতিমধ্যেই।
আরও পড়ুন: পুজোর পরেই ভোটের প্রস্তুতি? সোশ্যাল মিডিয়ায় প্রচারকে জোরদার করতে অভিষেকের ঘোষণা ডিজিটাল যুদ্ধর...
কারণ কী?
জানা গিয়েছে, মুখ্যমন্ত্রী ভূপেন্দ্র প্যাটেলের ক্যাবিনেট অর্থাৎ গুজরাট মন্ত্রীসভার রদবদল, সম্প্রসারণ হবে। আগামিকাল অর্থাৎ শুক্রবার তা হওয়ার সম্ভাবনা রয়েছে। গেরুয়া শিবির সূত্রে খবর, প্রায় ১০জন নতুন মন্ত্রীকে মন্ত্রিসভায় অন্তর্ভুক্ত করা হতে পারে। বর্তমান মন্ত্রীদের প্রায় অর্ধেকের বেশি সংখ্যক মন্ত্রীকে ফিরিয়ে আনা হবে নতুন মন্ত্রিসভায়। রদবদলের আগে, ঠিক সেই কারণেই মুখ্যমন্ত্রী ছাড়া বাকি সব মন্ত্রী পদত্যাগ করেছেন।
সর্বভারতীয় সংবাদ সংস্থা সূত্রে খবর, সে রাজ্যের সরকারি এক বিজ্ঞপ্তিতে জানানো হয়েছে, শুক্রবার সকাল ১১:৩০ টায় গুজরাটের মুখ্যমন্ত্রী ভূপেন্দ্র প্যাটেলের মন্ত্রিসভা সম্প্রসারিত হবে। আজ অর্থাৎ বৃহস্পতিবার বাকি মন্ত্রীদের পদত্যাগপত্র গ্রহণ করার পর, ভূপেন্দ্র প্যাটেল সে রাজ্যের রাজ্যপাল আচার্য দেবব্রতর সঙ্গে দেখা করবেন।
মুখ্যমন্ত্রী-সহ, বর্তমানে গুজরাট মন্ত্রিসভায় ১৭ জন মন্ত্রী রয়েছেন। আটজন মন্ত্রিপারিষদ পদমর্যাদার এবং সমান সংখ্যক প্রতিমন্ত্রী (MoS)হিসেবে দায়িত্ব পালন করছেন। গুজরাটের রাজ্য বিধানসভার মোট সদস্য সংখ্যা ১৮২। নিয়ম অনুযায়ী, গুজরাটে সর্বাধিক ২৭ জন মন্ত্রী থাকতে পারেন, যা মোট সদস্য সংখ্যার ১৫ শতাংশ। এই মাসের শুরুতে, প্রতিমন্ত্রী জগদীশ বিশ্বকর্মাকে ভারতীয় জনতা পার্টির গুজরাট ইউনিটের নতুন সভাপতি হিসেবে নিযুক্ত করা হয়েছিল, তিনি কেন্দ্রীয় মন্ত্রী সি.আর. পাতিলের স্থলাভিষিক্ত হন।

নানান খবর

জাতগণনা নিয়ে স্পষ্ট বার্তা দিলেন নারায়ণ এবং সুধা মূর্তি, শুরু বিতর্ক

৯ শতাংশ উপজাতি ভোট বিহারের জটিল রাজনৈতিক পরিস্থিতির ভারসাম্য নষ্ট করতে পারে, তুরুপের তাস মুকেশ সাহানি

ট্রাম্পের মন্তব্যে কি প্রকাশ্যে চলে এল মোদির কূটনৈতিক ব্যর্থতা? ভারতের প্রধানমন্ত্রীর রিমোট মার্কিন প্রেসিডেন্টের হাতে?

ইন্দোরে রূপান্তরকামীকে 'ধর্ষণ'! প্রতিবাদে ফিনাইল খেয়ে হাসপাতালে ভর্তি ২৫ জন রূপান্তরকামী!

গুণধর ছেলে, মাওবাদীদের নাম করে বাবাকে হুমকি চিঠি! ৩৫ লাখ আদায়ের চেষ্টা, শেষে কী হল?

বিহারে ভোটার বাদ পড়া নিয়ে নতুন বিতর্ক: বিরোধীদের ঘাঁটিতেই সবচেয়ে বেশি ভোটার বাদ গেছে!

দক্ষিণ এশিয়ার বিশ্ববিদ্যালয়ে ছাত্রীকে গণধর্ষণের চেষ্টা, দেরিতে এফআইআর দায়ের ঘিরে বিক্ষোভে উত্তাল ক্যাম্পাস

অবশেষে সমাধান হল দলিত আইপিএস অফিসার ওয়াই.পুরণ কুমারের ময়নাতদন্ত সংক্রান্ত অচলাবস্থা

আসলেন, টিকিট কাটলেন, মেট্রোয় চড়ে ভিক্ষে করতে শুরু করে দিলেন! বেঙ্গালুরুর স্মার্ট ভিক্ষুকের ভিডিও ভাইরাল

বিহার ভোটে দ্বিতীয় দফার প্রার্থী তালিকা ঘোষণা করল বিজেপি, রয়েছে বিরাট চমক

অপারেশন সিন্দুরের সময় কোন পদক্ষেপ নিয়েছিল ভারতীয় নৌবাহিনী যা এখনও কেউ জানে না, জানালেন ডিজিএমও

শীতের আগেই ভয়ের দাপট দিল্লিতে, চলছে আগাম প্রস্তুতি

কে কে ভালবাসে, মারা গেলে কষ্ট পাবে? জানার জন্য 'মৃত' সেজে অভিনয়! চিতায় আগুন দেওয়ার আগেই নাটকীয় মোড়

গ্রামে রাস্তাই নেই! ঢুকল না অ্যাম্বুল্যান্স, 'ডোলি'তে যুবতীর দেহ কাঁধে নিয়ে ১২ কিমি পথ পায়ে হাঁটলেন আত্মীয়রা

শিশুর জীবনের মূল্য মাত্র আড়াই টাকা! প্রেসক্রিপশনে কোল্ডরিফ লিখে বোতল প্রতি এত টাকা পেয়েছিলেন ডাক্তার
দাঁত থেকে ক্রমাগত রক্ত পড়ে? ব্লাড ক্যানসার নয় তো? কীভাবে চিনবেন এই মারণরোগ?

'ব্লাড-গ্রুপ' বাধা এখন অতীত! যুগান্তকারী আবিষ্কারে তৈরি হল 'ইউনিভার্সাল' কিডনি

পোলাও-মাংস-বিরিয়ানি যাই খাবেন হজম হবে দুই মিনিটে! ঘুমানোর আগে ঢকঢক করে পান করুন একটিমাত্র মশলা ভেজানো পানীয়

পর পর তিনবার! পাড়া কাঁপিয়ে ফের গুলি চলল কপিল শর্মার রেস্তরাঁয়, দায় স্বীকার করল কোন কুখ্যাত গ্যাংস্টারের দল?

অন্যের শ্বাস নেওয়া বা খাওয়ার শব্দে বিরক্ত হন? আপনি ‘মিসোফোনিয়া’য় আক্রান্ত নন তো? জানেন কী এই মানসিক রোগ?

বেনজির, বিশ্বের সবচেয়ে শক্তিশালী প্রথম ১০ পাসপোর্ট তালিকা থেকে বাদ আমেরিকা! কী অবস্থা ভারতের?

সুপার কাপ থেকে নাম প্রত্যাহার রিয়াল কাশ্মীরের, মোহনবাগান-ইস্টবেঙ্গলের সঙ্গে একই গ্রুপে খেলছে ডেম্পো

এশিয়া কাপে বেধড়ক পেটানোর ফল, সেপ্টেম্বরে আইসিসি প্লেয়ার অফ দ্য মান্থ অভিষেক শর্মা, মহিলাদের তরফে সেরার নাম চমকে দেবে

Exclusive: 'শেকড়'-এর টানে অচেনা লোকনাথ! বোলপুরে ভোলবদল করে কী জানালেন অভিনেতা?

'কাপটা চিনতে পারেন...', নকভিকে খোঁচা দিলেন ভারতের রহস্য স্পিনার বরুণ, কোথায় পেলেন ট্রফি?

ফের রাজ্যে জাল ওষুধ কারবারের পর্দা ফাঁস, সতর্ক ড্রাগ কন্ট্রোল সহ রাজ্য প্রশাসনও

এত সম্পত্তি, আরও টাকা চাই? পান মশলার বিজ্ঞাপন নিয়ে শাহরুখকে কী কী কটাক্ষ ইউটিউবার ধ্রুব রাঠীর?

দিনভর কাজের পর পা টনটন করছে? প্রয়োগ করুন ‘থার্মোথেরাপি’, কীভাবে কাজ করে এই টোটকা?

যদি হঠাৎ সূর্যের আলো নিভে যায়, কতক্ষণ টিকবে পৃথিবী?

'তোমায় বিয়ে করব', সম্পর্কের ঘনিষ্ঠতা বাড়িয়েই লক্ষ লক্ষ টাকার প্রতারণা, হুগলিতে 'প্রেমের ফাঁদ' দেখে চমকে উঠছেন স্থানীয়রা

বুদ্ধদেব ভট্টাচার্যের আমলেই বাংলায় সবচেয়ে বেশি খুন-ধর্ষণ হয়েছে: সাংসদ কল্যাণ ব্যানার্জি

‘সবার প্রিয় ছিল, দুরন্ত সব গল্প বলতে পারত...’ ‘কর্ণ’ পঙ্কজ ধীরকে হারিয়ে ভেঙে পড়লেন ‘কৃষ্ণ’
দীপাবলির আগে চাঙ্গা হল বাজার, চওড়া হাসি বিনিয়োগকারীদের মুখে

'জন্মদিনে বাড়ুক অভিজ্ঞতা...', পরিবার-বন্ধুবান্ধব নিয়ে বিশেষ দিন কীভাবে কাটানোর প্ল্যান রাহুলের?

চোটের কবলে ম্যাক্সওয়েল, এবার অন্য ভূমিকায় অজি তারকা

‘শিলিগুড়িতে মহাকাল মন্দির তৈরির ইচ্ছে আছে, থাকবে সবচেয়ে বড় শিবমূর্তি’, দার্জিলিং থেকে ঘোষণা মমতার

নতুন সিইও আসতেই মাথায় হাত নেসলে কর্মীদের, কী ঘোষণা করলেন তিনি

নতুন রূপে ফিরছে 'অনুরাগের ছোঁয়া'র কৃষ্ণ ও জয়! কোন ধারাবাহিকে দেখা যাবে দুই অভিনেতাকে?